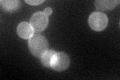
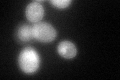
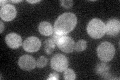

View description
GTP-binding alpha subunit of the heterotrimeric G protein that couples to pheromone receptors; negatively regulates the mating pathway by sequestering G(beta)gamma and by triggering an adaptive response; activates Vps34p at the endosome
Localization:
Intensity:
Fold change:
Significance:
-
C’ GFP library in SD
cell periphery52.29 -
N' NOP1pr-GFP in SD

cytosol255.953 -
N' TEF2pr-mCherry in SD

cytosol348.309 -
N' NATIVEpr-GFP in SD

below threshold18.54 -
N' TEF2pr-VC and Cyto-VN in SD

cytosol38.2062 -
C’ GFP library in SD+DTT
cell periphery55.971.07No -
C’ GFP library in SD+H2O2

cell periphery45.930.87No -
C’ GFP library in Starvation Media
cell periphery52.671No -
C’ GFP library on the background of Pup2-DaMP

cell periphery -
C’ GFP library on the background of CCT mutant

cell peripheryN/AN/ANo
